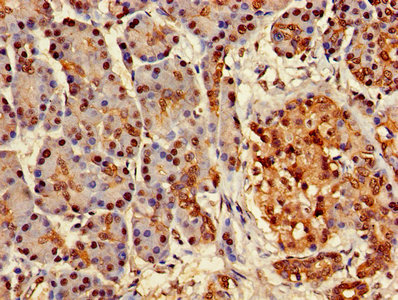
CSB-PA002443LA01HU

ATXN3
ATXN3,即Ataxin-3,別名A7LFZ5、ATX3、D6RDL9、E9PB63、MJD1、SCA3等。ATXN3由人類ATXN3基因編碼,該基因位于染色體14q32.1上。ATXN3在蛋白質(zhì)質(zhì)量控制和降解中發(fā)揮重要作用,通過去泛素化作用參與蛋白質(zhì)的降解和蛋白質(zhì)聚集的調(diào)控。ATXN3在神經(jīng)退行性疾病中扮演著重要角色,特別是在SCA3中。ATXN3的突變可能導(dǎo)致蛋白質(zhì)聚集和神經(jīng)細(xì)胞功能障礙。ATXN3的功能失常可能導(dǎo)致神經(jīng)元健康問題和其他神經(jīng)退行性疾病,在這些疾病中,ATXN3的異常調(diào)控可能影響神經(jīng)細(xì)胞的存活和功能。
熱銷產(chǎn)品
ATXN3 Antibody (CSB-PA002443LA01HU)
驗(yàn)證數(shù)據(jù)

Western blot
All lanes: ATXN3 antibody at 2µg/ml
Lane 1: 293T whole cell lysate
Lane 2: Mouse brain tissue
Lane 3: MCF-7 whole cell lysate
Secondary
Goat polyclonal to rabbit IgG at 1/10000 dilution
Predicted band size: 42, 36, 40, 21 kDa
Observed band size: 42 kDa

Immunohistochemistry of paraffin-embedded human lung cancer using CSB-PA002443LA01HU at dilution of 1:100
Immunohistochemistry of paraffin-embedded human pancreatic tissue using CSB-PA002443LA01HU at dilution of 1:100
ATXN3 Antibodies
ATXN3 for Homo sapiens (Human)
| 產(chǎn)品貨號(hào) | 產(chǎn)品名稱 | 種屬反應(yīng)性 | 應(yīng)用類型 |
|---|---|---|---|
| CSB-PA002443GA01HU | ATXN3 Antibody | Human,Mouse,Rat | ELISA,WB,IHC |
| CSB-PA002443LA01HU | ATXN3 Antibody | Human, Mouse | ELISA, WB, IHC |
ATXN3 Proteins
ATXN3 Proteins for Homo sapiens (Human)
| 產(chǎn)品貨號(hào) | 產(chǎn)品名稱 | 來源 |
|---|---|---|
| CSB-YP002443HU CSB-BP002443HU CSB-MP002443HU CSB-EP002443HU-B |
Recombinant Human Ataxin-3 (ATXN3) | Yeast Baculovirus Mammalian cell In Vivo Biotinylation in E.coli |
| CSB-EP002443HU | Recombinant Human Ataxin-3 (ATXN3) | E.coli |
ATXN3 Proteins for Rattus norvegicus (Rat)
| 產(chǎn)品貨號(hào) | 產(chǎn)品名稱 | 來源 |
|---|---|---|
| CSB-YP002443RA CSB-EP002443RA CSB-BP002443RA CSB-MP002443RA CSB-EP002443RA-B |
Recombinant Rat Ataxin-3 (Atxn3) | Yeast E.coli Baculovirus Mammalian cell In Vivo Biotinylation in E.coli |
ATXN3 Proteins for Mus musculus (Mouse)
| 產(chǎn)品貨號(hào) | 產(chǎn)品名稱 | 來源 |
|---|---|---|
| CSB-YP863445MO CSB-BP863445MO CSB-EP863445MO-B |
Recombinant Mouse Ataxin-3 (Atxn3) | Yeast Baculovirus In Vivo Biotinylation in E.coli |
ATXN3 Proteins for Gallus gallus (Chicken)
| 產(chǎn)品貨號(hào) | 產(chǎn)品名稱 | 來源 |
|---|---|---|
| CSB-YP894318CH CSB-EP894318CH CSB-BP894318CH CSB-MP894318CH CSB-EP894318CH-B |
Recombinant Chicken Ataxin-3 (ATXN3) | Yeast E.coli Baculovirus Mammalian cell In Vivo Biotinylation in E.coli |
















